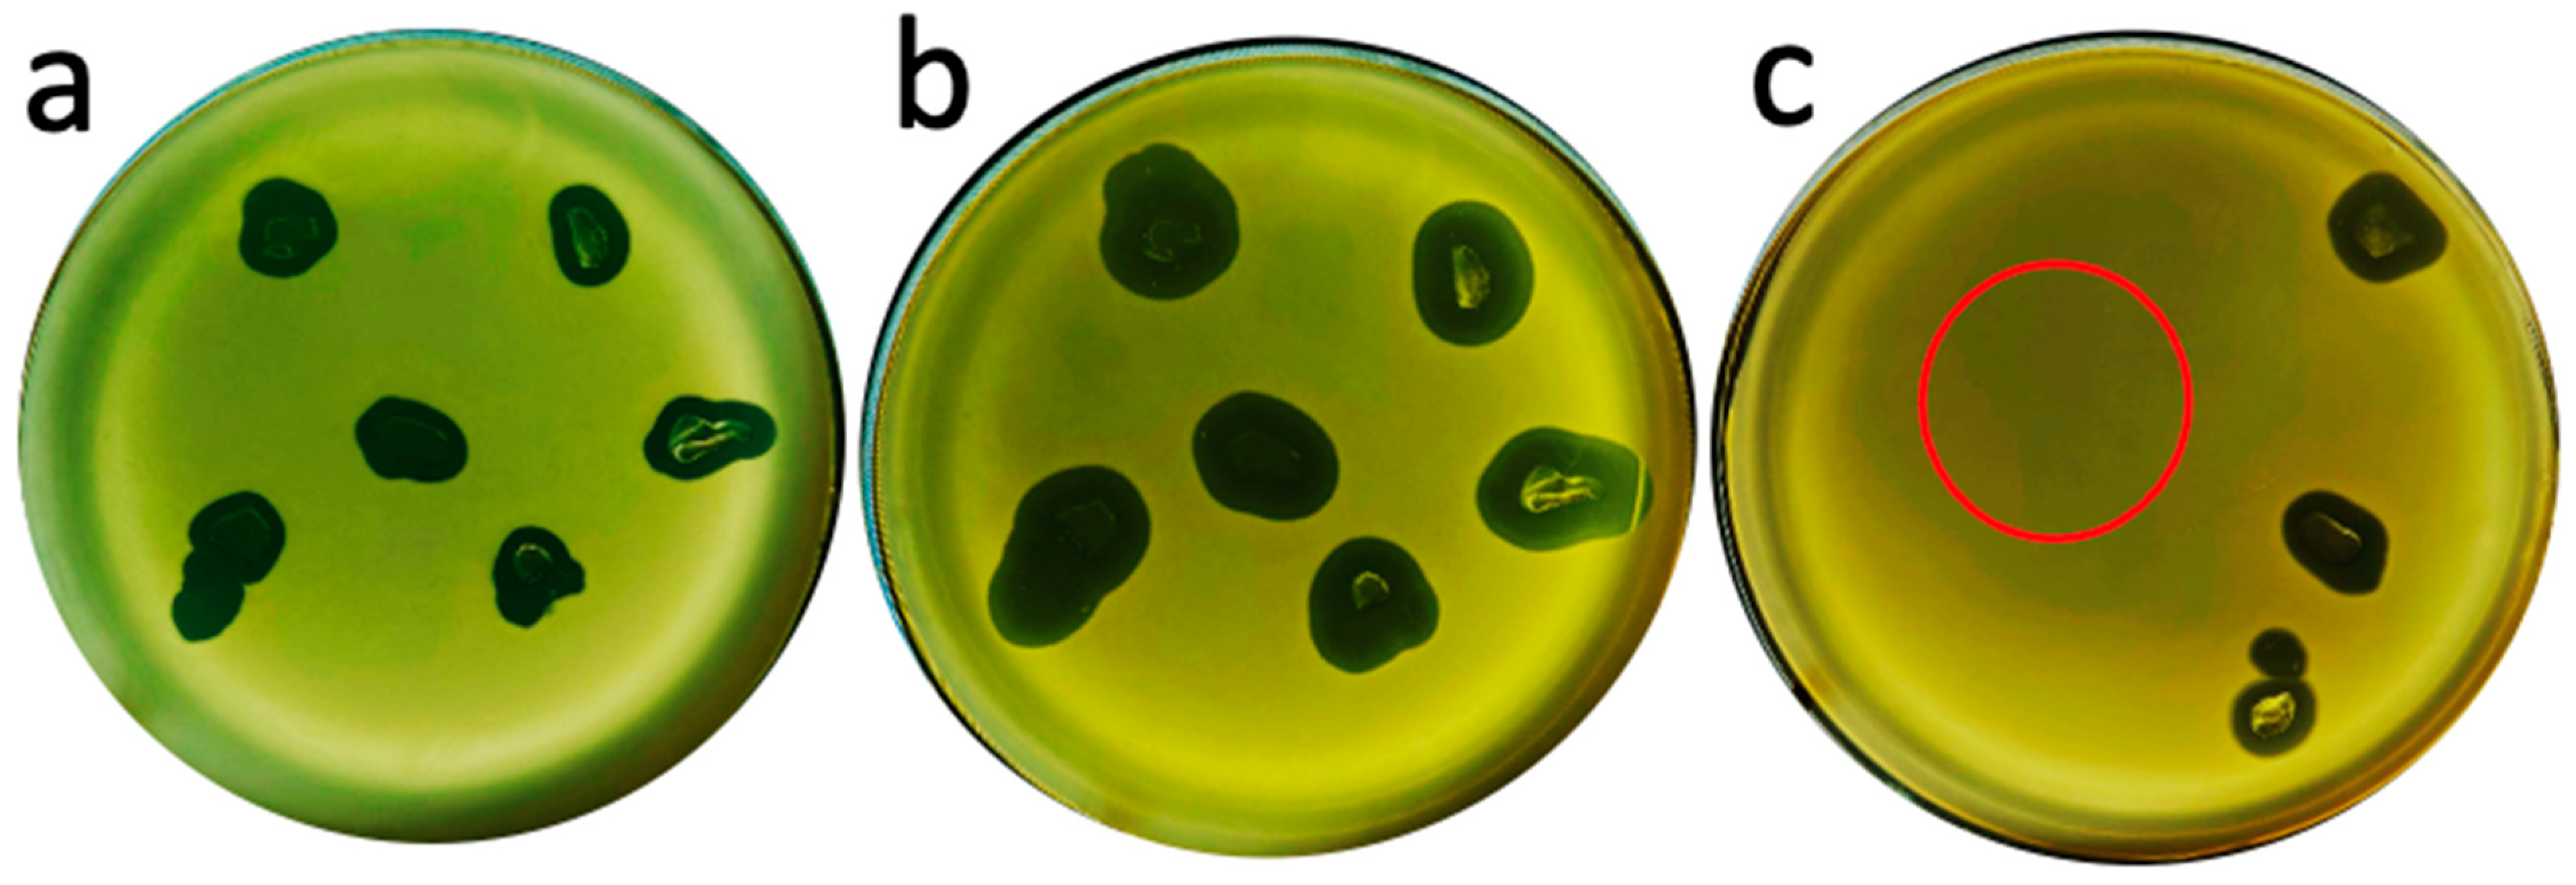
Ijms 26 02914 g008

Bypassing Evolution of Bacterial Resistance to Phages: The Example of Hyper-Aggressive Phage 0524phi7-1
Abstract
:1. Introduction
2. Results
2.1. Hyper-Aggressive Features
2.2. Fractionation and Genomic DNA
2.3. Electron Microscopy (EM) and Classification
2.4. State of In-Gel Propagating Phages: Transfer and Subsequent Propagation
3. Discussion
3.1. Improving Phage Therapy for Bacterial Infections
3.2. Analysis of Mechanistic Basics
3.3. The Future
4. Materials and Methods
4.1. Isolation and Propagation of Phages
4.2. Partial Purification of Phage 0524phi7-1
4.3. Agarose Gel Electrophoresis of DNA
4.4. Electron Microscopy
4.5. In-Gel Propagating Phage Transfer and Subsequent Propagation
4.6. Sequencing and Annotation of the 0524phi7-1 Genome
Supplementary Materials
Author Contributions
Funding
Institutional Review Board Statement
Informed Consent Statement
Data Availability Statement
Acknowledgments
Conflicts of Interest
References
- CDC (United States Centers for Disease Control and Prevention). Antibiotic Resistance Threats in the United States, 2019; 2019 AR Threats Report; Department of Health and Human Services, CDC: Atlanta, GA, USA, 2019; pp. 1–118. Available online: https://www.cdc.gov/antimicrobial-resistance/media/pdfs/2019-ar-threats-report-508.pdf (accessed on 21 July 2024).
- Ahmad, I.; Malak, H.A.; Abulreesh, H.H. Environmental antimicrobial resistance and its drivers: Apotential threat to public health. J. Glob. Antimicrob. Resist. 2021, 27, 101–111. [Google Scholar]
- World Health Organization. Antimicrobial Resistance. 2024. Available online: https://www.who.int/health-topics/antimicrobial-resistance (accessed on 21 July 2024).
- Keck, J.M.; Viteri, A.; Schultz, J.; Fong, R.; Whitman, C.; Poush, M.; Martin, M. New agents are coming, and so is the resistance. Antibiotics 2024, 13, 648. [Google Scholar] [CrossRef] [PubMed]
- Boccabella, L.; Palma, E.G.; Abenavoli, L.; Scarlata, G.G.M.; Boni, M.; Ianiro, G.; Santori, P.; Tack, J.F.; Scarpellini, E. Post-coronavirus disease 2019 pandemic antimicrobial resistance. Antibiotics 2024, 13, 233. [Google Scholar] [CrossRef]
- O’Neil, J. Antimicrobial Resistance: Tackling a Crisis for the Health and Wealth of Nations—The Review on Antimicrobial Resistance Chaired by Wellcome Website. 2014. Available online: https://wellcomecollection.org/works/rdpck35v (accessed on 21 July 2024).
- Hitchcock, N.M.; Devequi Gomes Nunes, D.; Shiach, J.; Valeria Saraiva Hodel, K.; Dantas Viana Barbosa, J.; Alencar Pereira Rodrigues, L.; Coler, B.S.; Botelho Pereira Soares, M.; Badaró, R. Current clinical landscape and global potential of bacteriophage therapy. Viruses 2023, 15, 1020. [Google Scholar] [CrossRef]
- Centers for Disease Control and Prevention COVID-19: U.S. Impact on Antimicrobial Resistance, Special Report. 2022. Available online: https://www.cdc.gov/antimicrobial-resistance/media/pdfs/covid19-impact-report-508.pdf. (accessed on 22 March 2025).
- Kumar, N.R.; Balraj, T.A.; Kempegowda, S.N.; Prashant, A. Multidrug-resistant sepsis: A critical healthcare challenge. Antibiotics 2024, 13, 46. [Google Scholar] [CrossRef]
- Matta-Gutiérrez, G.; García-Morales, E.; García-Álvarez, Y.; Álvaro-Afonso, F.J.; Molines-Barroso, R.J.; Lázaro Martínez, J.L. The influence of multidrug-resistant bacteria on clinical outcomes of diabetic foot ulcers: A systematic review. J. Clin. Med. 2021, 10, 1948. [Google Scholar] [CrossRef]
- Strathdee, S.A.; Hatfull, G.F.; Mutalik, V.K.; Schooley, R.T. Phage therapy: From biological mechanisms to future directions. Cell 2023, 186, 17–31. [Google Scholar] [PubMed]
- Wang, B.; Du, L.; Dong, B.; Kou, E.; Wang, L.; Zhu, Y. Current knowledge and perspectives of phage therapy for combating refractory wound infections. Int. J. Mol. Sci. 2024, 25, 5465. [Google Scholar] [CrossRef]
- Khosravi, A.; Chen, Q.; Echterhof, A.; Koff, J.L.; Bollyky, P.L. Phage therapy for respiratory infections: Opportunities and challenges. Lung 2024, 202, 223–232. [Google Scholar]
- McCallin, S.; Sacher, J.C.; Zheng, J.; Chan, B.K. Current state of compassionate phage therapy. Viruses 2019, 11, 343. [Google Scholar] [CrossRef]
- Young, J.; Mehta, N.; Lee, S.W.; Rodriguez, E.K. How effective is phage therapy for prosthetic joint infections? A preliminary systematic review and proportional meta-analysis of early outcomes. Medicina 2024, 60, 790. [Google Scholar] [CrossRef] [PubMed]
- Hibstu, Z.; Belew, H.; Akelew, Y.; Mengist, H.M. Phage therapy: A different approach to fight bacterial infections. Biologics 2022, 16, 173–186. [Google Scholar] [PubMed]
- Azam, A.H.; Tan, X.-E.; Veeranarayanan, S.; Kiga, K.; Cui, L. Bacteriophage technology and modern medicine. Antibiotics 2021, 10, 999. [Google Scholar] [CrossRef] [PubMed]
- Schooley, R.T.; Biswas, B.; Gill, J.J.; Hernandez-Morales, A.; Lancaster, J.; Lessor, L.; Barr, J.J.; Reed, S.L.; Rohwer, F.; Benler, S.; et al. Development and use of personalized bacteriophage-based therapeutic cocktails to treat a patient with a disseminated resistant Acinetobacter baumannii infection. Antimicrob. Agents Chemother. 2017, 61, e00954-17. [Google Scholar] [CrossRef]
- Smith, H.W.; Huggins, M.B. Successful treatment of experimental Escherichia coli infections in mice using phage: Its general superiority over antibiotics. J. Gen. Microbiol. 1982, 128, 307–318. [Google Scholar]
- Shi, Z.; Zhang, J.; Tian, L.; Xin, L.; Liang, C.; Ren, X.; Li, M. A Comprehensive overview of the antibiotics approved in the last two decades: Retrospects and prospects. Molecules 2023, 28, 1762. [Google Scholar] [CrossRef]
- Stahlmann, R.; Lode, H. Toxicity of quinolones. Drugs 1999, 58 (Suppl. S2), 37–42. [Google Scholar] [CrossRef]
- Scavone, C.; Mascolo, A.; Ruggiero, R.; Sportiello, L.; Rafaniello, C.; Berrino, L.; Capuano, A. Quinolones-induced musculoskeletal, neurological, and psychiatric ADRs: A pharmacovigilance study based on data from the Italian spontaneous reporting system. Front. Pharmacol. 2020, 11, 428. [Google Scholar]
- Medicines and Healthcare Products Regulatory Agency, GOV.UK. Fluoroquinolone Antibiotics: Reminder of the Risk of Disabling and Potentially Long-Lasting or Irreversible Side Effects. 2023. Available online: https://www.gov.uk/drug-safety-update/fluoroquinolone-antibiotics-reminder-of-the-risk-of-disabling-and-potentially-long-lasting-or-irreversible-side-effects. (accessed on 22 March 2025).
- Yang, Q.; Le, S.; Zhu, T.; Wu, N. Regulations of phage therapy across the world. Front. Microbiol. 2023, 14, 1250848. [Google Scholar] [CrossRef]
- Serwer, P.; Wright, E.T.; De La Chapa, J.; Gonzales, C.B. Basics for improved use of phages for therapy. Antibiotics 2021, 10, 723. [Google Scholar] [CrossRef]
- Chambers, J.P.; Aldis, M.; Thomas, J.A.; Gonzales, C.B.; White, R.A., III.; Serwer, P. Biophysical breakthroughs projected for the phage therapy of bacterial disease. Biophysica 2024, 4, 195–206. [Google Scholar] [CrossRef]
- Zhang, M.; Zhang, T.; Yu, M.; Chen, Y.L.; Jin, M. The life cycle transitions of temperate phages: Regulating factors and potential ecological implications. Viruses 2022, 14, 1904. [Google Scholar] [CrossRef] [PubMed]
- Feiner, R.; Argov, T.; Rabinovich, L.; Sigal, N.; Borovok, I.; Herskovits, A.A. A new perspective on lysogeny: Prophages as active regulatory switches of bacteria. Nat. Rev. Microbiol. 2015, 13, 641–650. [Google Scholar] [CrossRef] [PubMed]
- Pathria, S.; Rolando, M.; Lieman, K.; Hayes, S.; Hardies, S.; Serwer, P. Islands of non-essential genes, including a DNA translocation operon, in the genome of bacteriophage 0305ϕ8-36. Bacteriophage 2012, 2, 25–35. [Google Scholar] [CrossRef] [PubMed]
- Hesse, S.; Rajaure, M.; Wall, E.; Johnson, J.; Bliskovsky, V.; Gottesman, S.; Adhya, S. Phage resistance in multidrug resistant Klebsiella pneumoniae ST258 evolves via diverse mutations that culminate in impaired adsorption. mBio 2020, 11, e02530-19. [Google Scholar] [CrossRef]
- Fong, K.; Mu, K.; Rheault, J.G.; Levesque, R.C.; Kitts, D.D.; Delaquis, P.; Goodridge, L.; Wang, S. Bacteriophage insensitive mutants of antimicrobial-resistant Salmonella enterica are altered in their tetracycline resistance and virulence in caco-2 intestinal cells. Int. J. Mol. Sci. 2020, 21, 1883. [Google Scholar] [CrossRef]
- Yoo, S.; Lee, K.-M.; Kim, N.; Vu, T.N.; Abadie, R.; Yong, D. Designing phage cocktails to combat the emergence of bacteriophage-resistant mutants in multidrug-resistant Klebsiella pneumoniae. Microbiol. Spectr. 2024, 12, e0125823. [Google Scholar] [CrossRef]
- Martinez-Soto, C.E.; McClelland, M.; Kropinski, A.M.; Lin, J.T.; Khursigara, C.M.; Anany, H. Multireceptor phage cocktail against Salmonella enterica to circumvent phage resistance. Microlife 2024, 5, uqae003. [Google Scholar] [CrossRef]
- Oechslin, F. Resistance development to bacteriophages occurring during bacteriophage therapy. Viruses 2018, 10, 351. [Google Scholar] [CrossRef]
- Serwer, P.; Wright, E.T. Gated ethidium- and bleomycin-loading in phage T4 that is subsequently purified leak-free. Biophysica 2022, 2, 366–380. [Google Scholar] [CrossRef]
- Serwer, P.; Wright, E.T. In-gel isolation and characterization of large (and other) phages. Viruses 2020, 12, 410. [Google Scholar] [CrossRef] [PubMed]
- Barylski, J.; Kropinski, A.M.; Alikhan, N.F.; Adriaenssens, E.M. Ictv report consortium. ICTV virus taxonomy profile. Herelleviridae. J. Gen. Virol. 2020, 101, 362–363. [Google Scholar] [PubMed]
- Webber, D.M.; Wallace, M.A.; Burnham, C.D. Stop waiting for tomorrow: Disk diffusion performed on early growth is an accurate method for antimicrobial susceptibility testing with reduced turnaround time. J. Clin. Microbiol. 2022, 60, e03007-20. [Google Scholar]
- Humphries, R.M.; Kircher, S.; Ferrell, A.; Krause, K.M.; Malherbe, R.; Hsiung, A.; Burnham, C.-A.D. The continued value of disk diffusion for assessing antimicrobial susceptibility in clinical laboratories: Report from the Clinical and Laboratory Standards Institute Methods Development and Standardization Working Group. J. Clin. Microbiol. 2018, 56, e00437-18. [Google Scholar]
- Mommaerts, V.; Jans, K.; Smagghe, G. Impact of Bacillus thuringiensis strains on survival, reproduction and foraging behaviour in bumblebees (Bombus terrestris). Pest Manag Sci. 2010, 66, 520–525. [Google Scholar]
- Steinigeweg, C.; Alkassab, A.T.; Erler, S.; Beims, H.; Wirtz, I.P.; Richter, D.; Pistorius, J. Impact of a microbial pest control product containing Bacillus thuringiensis on brood development and gut microbiota of Apis mellifera worker honey bees. Microb. Ecol. 2023, 85, 1300–1307. [Google Scholar]
- Ritter, S.; Wright, E.T.; Serwer, P. Extracellular interaction of Bacillus thuringiensis, ATP and phage 0105phi7-2: A potential new anti-bacterial strategy. Viruses 2023, 15, 2409. [Google Scholar] [CrossRef]
- Serysheva, I.I.; Tourkin, A.I.; Bartish, I.V.; Poglazov, B.F. GTPase activity of bacteriophage T4 sheath protein. J. Mol.Biol. 1992, 223, 23–25. [Google Scholar]
- Aksyuk, A.A.; Leiman, P.G.; Kurochkina, L.P.; Shneider, M.M.; Kostyuchenko, V.A.; Mesyanzhinov, V.V.; Rossmann, M.G. The tail sheath structure of bacteriophage T4: A molecular machine for infecting bacteria. EMBO J. 2009, 28, 821–829. [Google Scholar] [CrossRef]
- Bryan, D.; El-Shibiny, A.; Hobbs, Z.; Porter, J.; Kutter, E.M. Bacteriophage T4 infection of stationary phase E. coli: Life after log from a phage perspective. Front. Microbiol. 2016, 7, 1391. [Google Scholar]
- Los, M.; Wegrzyn, G.; Neubauer, P. A role for bacteriophage T4 rI gene function in the control of phage development during pseudolysogeny and in slowly growing host cells. Res. Microbiol. 2003, 154, 547–552. [Google Scholar] [CrossRef] [PubMed]
- Summers, W.C. The American Phage Group: Founders of Molecular Biology; Yale University Press: New Haven, CT, USA, 2023. [Google Scholar]
- Serwer, P.; Hayes, S.J.; Zaman, S.; Lieman, K.; Rolando, M.; Hardies, S.C. Improved isolation of undersampled bacteriophages: Finding of distant terminase genes. Virology 2004, 329, 412–424. [Google Scholar] [CrossRef]
- Serwer, P.; Wright, E.T.; Liu, Z.; Jiang, W. Length quantization of DNA partially expelled from heads of a bacteriophage T3 mutant. Virology 2014, 456–457, 157–170. [Google Scholar]
- Robinson, L.H.; Landy, A. HindII, HindIII, and HpaI restriction fragment maps of bacteriophage lambda DNA. Gene 1977, 2, 1–31. [Google Scholar] [PubMed]
- Pajunen, M.I.; Elizondo, M.R.; Skurnik, M.; Kieleczawa, J.; Molineux, I.J. Complete nucleotide sequence and likely recombinatorial origin of bacteriophage T3. J. Mol. Biol. 2002, 319, 1115–1132. [Google Scholar]
- Miller, E.S.; Kutter, E.; Mosig, G.; Arisaka, F.; Kunisawa, T.; Rüger, W. Bacteriophage T4 genome. Microbiol. Mol. Biol. Rev. 2003, 67, 86–156. [Google Scholar]
- Roberts, S.M.; Aldis, M.; Wright, E.T.; Gonzales, C.B.; Lai, Z.; Weintraub, S.T.; Hardies, S.C.; Serwer, P. Siphophage 0105phi7-2 of Bacillus thuringiensis: Novel propagation, DNA, and genome-implied assembly. Int. J. Mol. Sci. 2023, 24, 8941. [Google Scholar] [CrossRef]

Disclaimer/Publisher’s Note: The statements, opinions and data contained in all publications are solely those of the individual author(s) and contributor(s) and not of MDPI and/or the editor(s). MDPI and/or the editor(s) disclaim responsibility for any injury to people or property resulting from any ideas, methods, instructions or products referred to in the content. |
© 2025 by the authors. Licensee MDPI, Basel, Switzerland. This article is an open access article distributed under the terms and conditions of the Creative Commons Attribution (CC BY) license (https://creativecommons.org/licenses/by/4.0/).
Share and Cite
Rojero, M.; Weaver-Rosen, M.; Serwer, P. Bypassing Evolution of Bacterial Resistance to Phages: The Example of Hyper-Aggressive Phage 0524phi7-1. Int. J. Mol. Sci. 2025, 26, 2914. https://doi.org/10.3390/ijms26072914
Rojero M, Weaver-Rosen M, Serwer P. Bypassing Evolution of Bacterial Resistance to Phages: The Example of Hyper-Aggressive Phage 0524phi7-1. International Journal of Molecular Sciences. 2025; 26(7):2914. https://doi.org/10.3390/ijms26072914
Chicago/Turabian StyleRojero, Maria, Meagan Weaver-Rosen, and Philip Serwer. 2025. "Bypassing Evolution of Bacterial Resistance to Phages: The Example of Hyper-Aggressive Phage 0524phi7-1" International Journal of Molecular Sciences 26, no. 7: 2914. https://doi.org/10.3390/ijms26072914
APA StyleRojero, M., Weaver-Rosen, M., & Serwer, P. (2025). Bypassing Evolution of Bacterial Resistance to Phages: The Example of Hyper-Aggressive Phage 0524phi7-1. International Journal of Molecular Sciences, 26(7), 2914. https://doi.org/10.3390/ijms26072914






